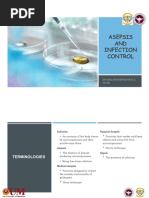

0% found this document useful (0 votes)
159 views5 pagesHand Hygiene for Healthcare Workers
The document discusses proper handwashing techniques in a healthcare setting. It outlines the steps for handwashing, which include wetting hands, applying soap, rubbing hands together for 10-30 seconds, rinsing thoroughly, and drying with a towel. Handwashing is the most effective way to reduce transmission of infections and should be done before and after contact with patients, after contact with body fluids, and when gloves are removed. Proper handwashing helps remove microorganisms and prevents the spread of infections in hospitals.
Uploaded by
Kristine CustodioCopyright
© © All Rights Reserved
We take content rights seriously. If you suspect this is your content, claim it here.
Available Formats
Download as DOCX, PDF, TXT or read online on Scribd
0% found this document useful (0 votes)
159 views5 pagesHand Hygiene for Healthcare Workers
The document discusses proper handwashing techniques in a healthcare setting. It outlines the steps for handwashing, which include wetting hands, applying soap, rubbing hands together for 10-30 seconds, rinsing thoroughly, and drying with a towel. Handwashing is the most effective way to reduce transmission of infections and should be done before and after contact with patients, after contact with body fluids, and when gloves are removed. Proper handwashing helps remove microorganisms and prevents the spread of infections in hospitals.
Uploaded by
Kristine CustodioCopyright
© © All Rights Reserved
We take content rights seriously. If you suspect this is your content, claim it here.
Available Formats
Download as DOCX, PDF, TXT or read online on Scribd
/ 5